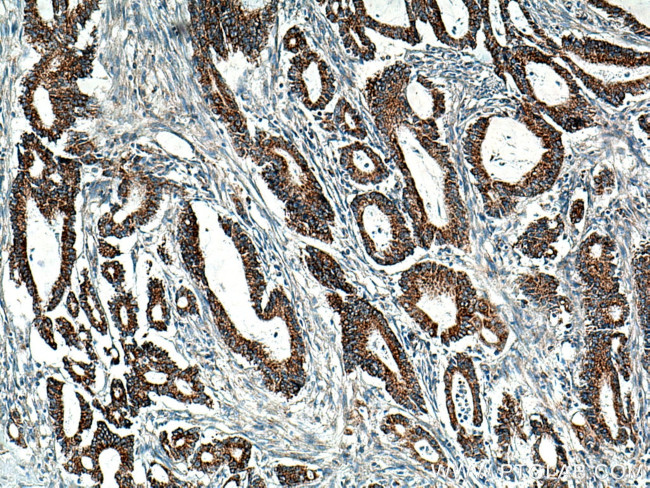
BCKDHB Antibody in Immunohistochemistry (Paraffin) (IHC (P))

Search
Proteintech
BCKDHB Polyclonal Antibody
{{$productOrderCtrl.translations['antibody.pdp.commerceCard.promotion.promotions']}}
{{$productOrderCtrl.translations['antibody.pdp.commerceCard.promotion.viewpromo']}}
{{$productOrderCtrl.translations['antibody.pdp.commerceCard.promotion.promocode']}}: {{promo.promoCode}} {{promo.promoTitle}} {{promo.promoDescription}}. {{$productOrderCtrl.translations['antibody.pdp.commerceCard.promotion.learnmore']}}
产品信息
13685-1-AP
种属反应
已发表种属
宿主/亚型
分类
类型
抗原
偶联物
形式
浓度
规格
纯化类型
保存液
内含物
保存条件
运输条件
产品详细信息
Immunogen sequence: TVEDAAQRR QVAHFTFQPD PEPREYGQTQ KMNLFQSVTS ALDNSLAKDP TAVIFGEDVA FGGVFRCTVG LRDKYGKDRV FNTPLCEQGI VGFGIGIAVT GATAIAEIQF ADYIFPAFDQ IVNEAAKYRY RSGDLFNCGS LTIRSPWGCV GHGALYHSQS PEAFFAHCPG IKVVIPRSPF QAKGLLLSCI EDKNPCIFFE PKILYRAAAE EVPIEPYNIP LSQAEVIQEG SDVTLVAWGT QVHVIREVAS MAKEKLGVSC EVIDLRTIIP WDVDTICKSV IKTGRLLISH EAPLTGGFAS EISSTVQEEC FLNLEAPISR VCGYDTPFPH IFEPFYIPDK WKCYDALRKM INY (41-392 aa encoded by BC040139)
靶标信息
Branched-chain keto acid dehydrogenase is a multienzyme complex associated with the inner membrane of mitochondria, and functions in the catabolism of branched-chain amino acids. The complex consists of multiple copies of 3 components: branched-chain alpha-keto acid decarboxylase (E1), lipoamide acyltransferase (E2) and lipoamide dehydrogenase (E3). This gene encodes the E1 beta subunit, and mutations therein have been associated with maple syrup urine disease (MSUD), type 1B, a disease characterized by a maple syrup odor to the urine in addition to mental and physical retardation, and feeding problems.
仅用于科研。不用于诊断过程。未经明确授权不得转售。
生物信息学
蛋白别名: 2-oxoisovalerate dehydrogenase beta subunit; 2-oxoisovalerate dehydrogenase subunit beta, mitochondrial; BCKD BCKDH E1-beta; BCKDE1B; BCKDH E1-beta; branched chain alpha-ketoacid dehydrogenase E1-beta subunit; branched chain keto acid dehydrogenase E1 beta; branched chain keto acid dehydrogenase E1, beta polypeptide; Branched-chain alpha-keto acid dehydrogenase E1 component beta chain; dJ279A18.1; E1b-beta subunit of the branched-chain complex; testis secretory sperm-binding protein Li 240mP; unnamed protein product
基因别名: BCKDE1B; BCKDH E1-beta; BCKDHB; E1B; MSUD1B; OVD1B
UniProt ID: (Human) P21953, (Rat) P35738, (Mouse) Q6P3A8
Entrez Gene ID: (Human) 594, (Rat) 29711, (Mouse) 12040